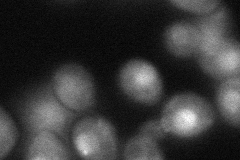
YER133W
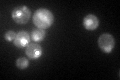
YER133W

View description
Type 1 serine/threonine protein phosphatase catalytic subunit, involved in many processes (eg: glycogen metabolism, sporulation, mitosis); accumulates at mating projections by interaction with Afr1p; interacts with many regulatory subunits
Localization:
Intensity:
Fold change:
Significance:
-
C’ GFP library in SD

punctate:nucleus159.53 -
N' NOP1pr-GFP in SD

bud neck,nucleus158.011 -
N' TEF2pr-mCherry in SD

nucleus,nucleolus247.681 -
N' NATIVEpr-GFP in SD

missing0 -
N' TEF2pr-VC and Cyto-VN in SD
punctate,nucleus61.5829 -
C’ GFP library in SD+DTT

punctate.nucleus180.381.13No -
C’ GFP library in SD+H2O2

punctate.nucleus134.270.84No -
C’ GFP library in Starvation Media
punctate,nucleus128.570.8No -
C’ GFP library on the background of Pup2-DaMP

punctate:nucleus -
C’ GFP library on the background of CCT mutant

punctate:nucleus220.8131.3841Yes
